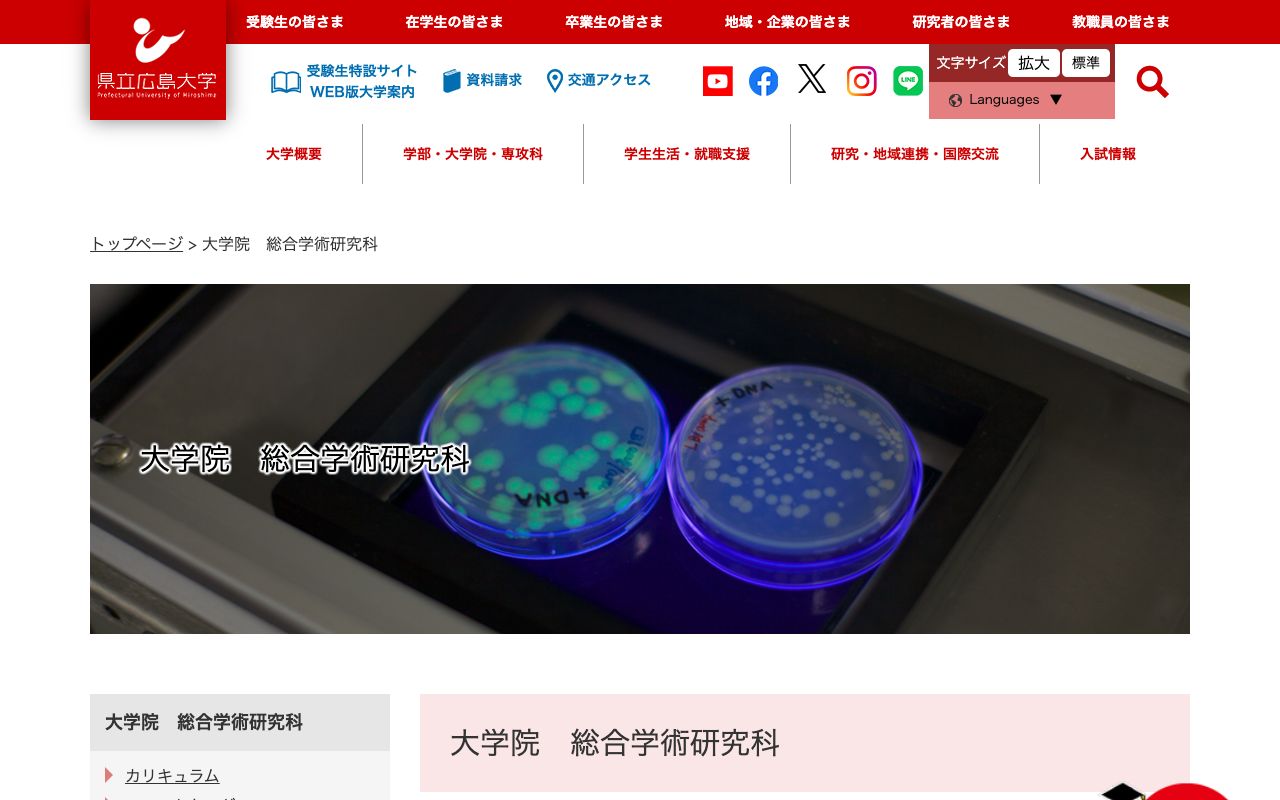
県立広島大学大学院 公式サイト

費用と給付金
受講費用¥1,466,400
教育訓練給付金(70%)-¥560,000
実質負担額¥906,400
※ 給付金の受給には雇用保険の被保険者期間等の条件があります。詳しくはハローワークにお問い合わせください。
講座情報
- 講座名
- 経営管理研究科ビジネスリーダーシップ専攻
- 制度種別
- 専門実践教育訓練
- 受講方法
- 通学
- 訓練期間
- 24ヶ月
スクール情報
- 学校名
- 県立広島大学大学院
- 所在地
- 〒734-8558 広島県広島市南区宇品東1-1-71
- 電話番号
- 082-251-9726
- 公式サイト
- pu-hiroshima.ac.jp
広島県の他の講座
一般社団法人 広島県介護支援専門員協会🔗
介護支援専門員専門研修課程II
受講費用¥22,000
給付金-¥8,800(40%)
実質負担¥13,200
特定一般教育訓練eラーニング4ヶ月広島県
教育・研修センターようき🔗
介護福祉士実務者研修通信講座(基礎研修修了者)
受講費用¥25,000
給付金-¥5,000(20%)
実質負担¥20,000
一般教育訓練通信eラーニング6ヶ月広島県
コベルコ教習所広島教習センター🔗
玉掛け技能講習(Hコース)
受講費用¥29,000
給付金-¥5,800(20%)
実質負担¥23,200
一般教育訓練通学1ヶ月広島県
山陽自動車学校🔗
フォークリフト(B)コース
受講費用¥29,150
給付金-¥11,660(40%)
実質負担¥17,490
特定一般教育訓練通学1ヶ月広島県
出典: 厚生労働省 教育訓練給付制度に基づく情報。 給付金額は目安であり、実際の支給額は受給要件や審査により異なる場合があります。 詳しくは最寄りのハローワークにお問い合わせください。